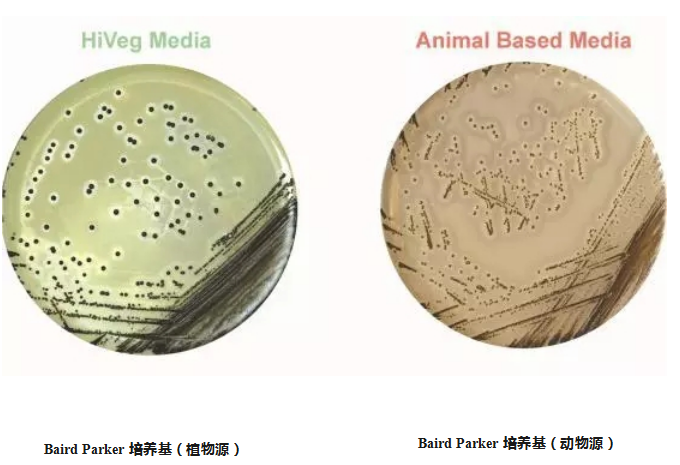

导航
导航
印度HiMedia的植物源蛋白胨是以植物成分为原料,经复合生物酶的酶解、膜分离提纯精制、喷雾干燥等一系列工艺制成。产品由不同分子量的胨、肽和氨基酸组成,营养丰富,可完全替代相应的动物蛋白胨产品,满足发酵、医疗、生物等行业各种微生物生长及细胞培养,同时安全性更高,可以有效避患免疯牛病风险。
用HiMedia植物蛋白胨培养的微生物产量更高,比动物蛋白胨平均高出13%左右,培养的菌落数量更多,体积更大,而价格却没有升高。如下图所示,虽为同一种菌,发现BairdParker植物源培养基菌落更大。由于植物蛋白胨的安全性更高,近年来越来越多的疫苗、抗体和干扰素等生物制药领域应用植物源蛋白胨生产产品。
有专家指出:与动物蛋白胨培养基相比较,使用植物蛋白胨培养基可提高肺炎球菌大罐培养浓度以及培养液多糖含量;精制多糖收率明显提高,各项质量指标均符合企业注册标准要求。植物性蛋白胨,相较胰蛋白胨来说,其相对分子质量较小,易于被细菌生长所吸收,且其碳水化合物总含量较高,能在细菌生长后期提供更多的营养物质来源,更易于细菌数量的积累及其后期荚膜的形成。
HiMedia公司是拥有植物源蛋白胨产品最多的公司。2003年开始,HiMedia公司开始研发植物源蛋白胨培养基及原料,至今已经有1500多种。
目前,北京华福恒远生物科技有限公司作为HiMedia品牌的中国地区总代理,将会一直把HiMedia植物源性培养基引入中国市场,为国内的生物制品提供更科学、更可靠的植物蛋白胨。
扫二维码用手机看
亚洲精品无码成人A片色欲-性视频播放免费视频-这里是国产精品视频一区二区-久久精品人妻av-国产丰满老熟妇乱XXX
公司地址:河南省濮阳县铁丘路路南中稹绿探院内3号楼
联系电话:13137349799
E-mail:[email protected]
性视频播放免费视频
公司地址:河南省濮阳县铁丘路路南中稹绿探院内3号楼
联系电话:18500199761
E-mail:[email protected]
© 2021 亚洲精品无码成人A片色欲-性视频播放免费视频-这里是国产精品视频一区二区-久久精品人妻av-国产丰满老熟妇乱XXX ALL Rights Reserved 备案号:豫ICP备2023018085号 技术支持:新网